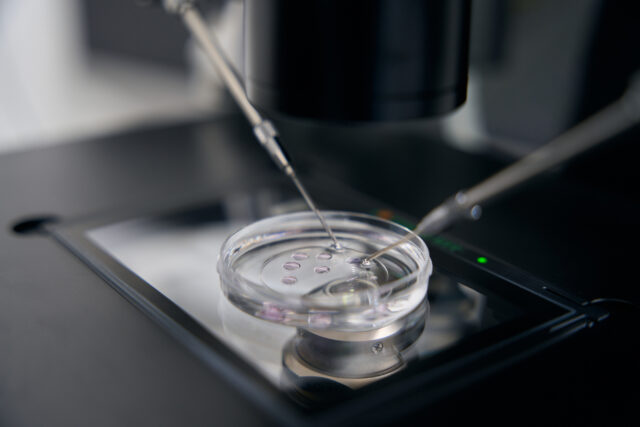

Freeze Dryer
In the realm of laboratory equipment, lyophilizers stand out as essential tools for researchers and scientists. These devices facilitate the process of freeze-drying, a critical technique in various fields such as pharmaceuticals, food preservation, and biotechnology. At Kalstein, we take pride in offering a wide range of lyophilizers that cater to diverse laboratory needs, ensuring high-quality results and optimal performance.
Our lyophilizers are designed with precision and advanced technology to provide efficient and reliable freeze-drying processes. With features such as precise temperature control, rapid freezing capabilities, and user-friendly interfaces, our lyophilizers guarantee seamless operations and consistent outcomes. Whether you are working on delicate biological samples or preserving perishable items, our lyophilizers are the perfect solution to meet your laboratory requirements. Trust Kalstein for top-notch lyophilizers that elevate your research endeavors.
Types of Freeze Dryer Your Laboratory may need
The tabletop laboratory freeze dryer
The tabletop laboratory freeze dryer, a subcategory of freeze dryers, is a compact and efficient solution for preserving samples in research and pharmaceutical settings. This equipment is designed to remove moisture from delicate samples without compromising their structure, ensuring long-term stability and usability. With user-friendly features and precise control systems, the tabletop freeze dryer offers convenience and reliability for laboratories of all sizes.
Ideal for limited space environments, the tabletop laboratory freeze dryer is easily manageable and requires minimal maintenance, making it a practical choice for various scientific applications. Its robust construction and advanced technology guarantee consistent results, allowing researchers to save time and resources while achieving optimal sample preservation. In today’s demanding laboratory settings, having a reliable and efficient freeze dryer like this tabletop model is essential for maintaining the integrity of valuable samples.
Vertical laboratory freeze-dryers
Vertical laboratory freeze-dryers are essential equipment for numerous scientific and industrial applications. Designed to remove moisture from delicate samples without compromising their integrity, vertical freeze dryers are known for their efficiency and reliability. These versatile machines efficiently freeze materials and then gently remove the ice through sublimation, ensuring that the final product retains its original shape and properties.
Kalstein offers a wide range of vertical laboratory freeze dryers to suit the unique needs of various industries. With precise temperature control and user-friendly interfaces, our freeze dryers are perfect for research laboratories, pharmaceutical companies, and food manufacturers. Whether you need to lyophilize proteins, microorganisms, or pharmaceutical products, Kalstein’s vertical freeze dryers guarantee consistent results and optimal performance for your laboratory processes. Trust Kalstein for all your freeze-drying needs.
FREEZE DRYER YUL GARY
At Yul Gary you can find the ideal Freeze Dryer for Your Laboratory
There are an infinite number of models, so it’s normal that you don’t know which Freeze Dryer to buy to meet your needs. At Yul Gary, we evaluate them to find what you are looking for.

Vertical Laboratory Freeze Dryer YG0271 // YG0274
Laboratory vacuum freeze dryer is widely used in medicine, pharmaceutical, biological research, chemical and food. The lyophilized articles are easy to store for a long tim...

Freeze Dryer Lyophilizer for Fruits and Vegetables YG0281
Lyophilization or freeze drying is a process in which water is removed from a product after it is frozen and placed under a vacuum, allowing the ice to chan...

Vertical Electric Heating Laboratory Freeze Dryer YG0275// YG0278
Laboratory vacuum freeze dryer is widely used in medicine, pharmaceutical, biological research, chemical and food. The lyophiliz...

Home Use Freeze Dryer For Food YG0279
Lyophilization or freeze drying is a process in which water is removed from a product after it is frozen and placed under a vacuum, allowing the ice to chan...
Our Freeze Dryer best seller
Freeze Dryer is suitable for freeze-drying experiment in laboratory. It is bench top T type equipment.
Freeze dryer is widely used in medicine, pharmacy, biology research, chemical industry and food production ,etc. After the freeze drying process,a long term preservation for products is much easier. They can be restored to the original state and maintain their chemical and biological characteristics after being watered.The vacuum freezing drying techinology, which is also called sublimation drying, is a technical method that freezes the samples in advance, and then sublimates its moisture in the vacuum state.
Features
- CFC Free refrigeration
- LCD display drying curves, English interface
- Big opening of condenser, condenser with pre-freezing function
- Low noise compressor, good efficiency,long service life
- Condenser and operation panel are all stainless steel
- Drying Chamber with organic glass is safe and visible
- Shelf and tray are stainless steel, tray spacing can be customized
- Small volume , easy and convenient operation
- Nitrogen valve is optional
- Eutectic point test device is optional
- Communication interface is optional
- Cascade refrigeration is optional , applied for -80℃ device
Model | YG0284 |
Condenser capacity | 3-4 kg /24h |
Condenser temperature | -55℃ (-80 ℃ optional ) |
Vacuum degree | < 10 Pa |
Rubber sealed valve | 24 pcs, for 24 ampoule , special requirement can be customized |
Cooling | Air, draughty, ambient temperature ≤25℃ |
Voltage | 220V ,50 Hz; 110V, 50Hz; 110V, 60Hz |
Host dimension | 460*625*(370+440) mm |
Host weight | 41 kg |
Power | 700W |
Analysis of the best Freeze Dryer for Your Laboratory

What is a freeze dryer?
The lyophilizer is the apparatus used to carry out lyophilization. It consists of the following parts: dry chamber or lyophilization chamber: it is the place where the substance to be lyophilized is place...
What technology does a lab freeze-drier use?
Freeze-drying is a laboratory process that has novel applications in the pharmaceutical and biotechnology industries, it is carried out in a laboratory instrument call...

Lyophilizers: What are its parts and maintenance?
The freeze-drier is a laboratory equipment used to carry out the freeze-drying process, which consists of removing the moisture present in a given product throu...

Why is it necessary to use a lyophilizer in a laboratory?
A lyophilizer is a laboratory instrument used to carry out the process of lyophilization, since this equipment is designed to remove moisture from a product ...
Catalog of models of Freeze Dryer on offer

Freeze Dryer Lyophilizer for Fruits and Vegetables YG0281
Add to cart
Benchtop Normal Lab Freeze Dryer YG0263
Add to cart
Benchtop Top Press Lab Freeze Dryer YG0264
Add to cart
Benchtop Manifold Lab Freeze Dryer YG0265
Add to cart
Home Use Freeze Dryer For Food YG0279
Add to cart
Food Freeze Dryer YG0280
Add to cart
Silicone Oil Heating Lyophilizer YG0281-1 // YG0281-2
Select options
Benchtop Manifold Top Press Lab Freeze Dryer YG0266
Add to cart
KALSTEIN UPDATED
Guidelines for you to become an expert in Freeze Dryer
The Freeze Dryer equipment are essential products in Your Laboratory, we provide you with guidance and recommendations for a better use, so you can work like an expert.
What are the criteria for selecting your ideal lyophilizer?
What A Laboratory Freeze-Dryer Is And What It Is For - Kalstein
The New Developments in Laboratory Freeze Dryers - Kalstein
What is a food freeze dryer?
Frequently asked questions from our customers about Freeze Dryer
To know the price of the freeze dryer we invite you to send us an email with your request using the contact form. HERE
The delivery time of your Kalstein product will depend on the following:
- Whether the equipment you are interested in is in stock or if it needs to be manufactured.
- The type of freight you have chosen, which can be either air or sea.
- Equipment in stock:
– Delivery Time (Air): 15-30 days.
– Delivery Time (Sea): 45-60 days.
- Equipment not in stock:
– Delivery Time (Air): 30-60 days.
– Delivery Time (Sea): 60-90 days.
You can make your purchase through:
- By email: [email protected]
- By phone: +33 (0) 1 70 39 26 50
- Online shopping: Through the official Kalstein website in your country.
All Kalstein equipment comes with a 1-year warranty against manufacturing defects. The warranty does not cover damages caused by improper installation or operation by the user, transportation defects, or uses other than those specified by the manufacturer. The warranty excludes electrical parts or consumables. For more information, visit our terms and conditions by clicking HERE.
At Kalstein, we provide our customers with inductions and technical support through new online methods. You can visit our induction videos, technical assistance, and guidance provided by a Kalstein team through our Youtube channel (Kalstein English). HERE
Certainly, you can request a quote for the Kalstein equipment you’re interested in, directly from our official website. Once you have identified the model of your preference, click HERE
Send us a direct message and one of our agents will contact you
Freeze Dryer
Lorem ipsum dolor sit amet, consectetur adipiscing elit. Sed dignissim placerat mauris cursus laoreet. Nam feugiat lacus ex, at fermentum sapien accumsan nec. Curabitur auctor porttitor mi non malesuada. Aenean condimentum, purus vitae rhoncus imperdiet, justo eros aliquam ipsum, at egestas leo diam eget libero.
Catalog of models of Freeze Dryer on offer.
- This product cannot be purchased.
-
YG2160 Chemiluminescence Analyzer
-
Moisture Analyzer YG2146
-
YG2159 Chemiluminescence Analyzer
-
Veterinary Operating Table YG2145
-
Veterinary Operating Table YG2144
-
Series Density Balance YG2154 //YG2154-4
This product has multiple variants. The options may be chosen on the product page -
YG2156 Benchtop Autoclave
-
YG2155 Recirculating Chiller
-
YG2113 Cooling Water Recirculation System
-
Real-Time PCR YG2139//YG2141
This product has multiple variants. The options may be chosen on the product page -
Intelligent Liquid Nitrogen Biological Container YG2153 Series//YG2153-2
This product has multiple variants. The options may be chosen on the product page -
YG2152//YG2152-3 Series Single and Dual Beam UV-Visible Spectrophotometer
This product has multiple variants. The options may be chosen on the product page -
High-Quality Vertical Laboratory Sterilizer with Color LCD Screen YG2151
-
YG2149-YG2150 Slide Drying Cabinet
-
Electric-Hydraulic Operating Table YG2143
-
Freeze Dryer YG2142
Descubre más de nuestro catálogo
Tipos de Freeze Dryer
[Producto] A
Lorem ipsum dolor sit amet, consectetur adipiscing elit. Ut elit tellus, luctus nec ullamcorper mattis, pulvinar dapibus leo.
[Producto] B
Lorem ipsum dolor sit amet, consectetur adipiscing elit. Ut elit tellus, luctus nec ullamcorper mattis, pulvinar dapibus leo.
Find out more about Freeze Dryer with our guides.
The Future of Veterinary Care: Exploring the Yulgary Veterinary Fundus Camera
Yulgary Veterinary Fundus Camera The Yulgary Veterinary Fundus Camera has become a pivotal tool in modern veterinary medicine. As someone...
The Ultimate Guide to Yulgary Electrosurgical Units: Precision, Innovation, and Value
Yulgary Electrosurgical Units: A Trusted Choice in Medical Innovation When it comes to electrosurgery, precision and reliability are paramount. Yulgary...
Revolutionize Your Food Quality Testing with Yulgary’s Food Safety Analyzer
Food Safety Analyzer by Yulgary In today's world, ensuring the safety and quality of food is not just a choice...





